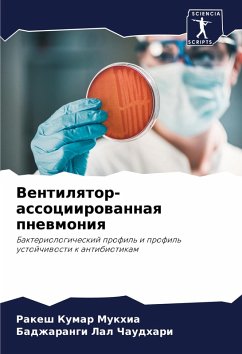
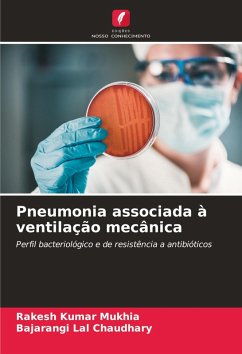

Suchergebnisse für ""Kumar M""
2920 Artikel gefunden
Zur ersten SeiteZur vorherigen Seite...Weitere Seiten 35 Zur Seite 35 36 Zur Seite 36 37 Zur Seite 37 38 Aktuelle Seite 39 Zur Seite 39 40 Zur Seite 40...Weitere Seiten59Zur letzten Seite, Seite 59Zur nächsten SeiteZur letzten Seite
Zur ersten SeiteZur vorherigen Seite...Weitere Seiten 37 Zur Seite 37 38 Aktuelle Seite...Weitere Seiten59Zur letzten Seite, Seite 59Zur nächsten SeiteZur letzten Seite
Ähnlichkeitssuche: Fact®Finder von OMIKRON